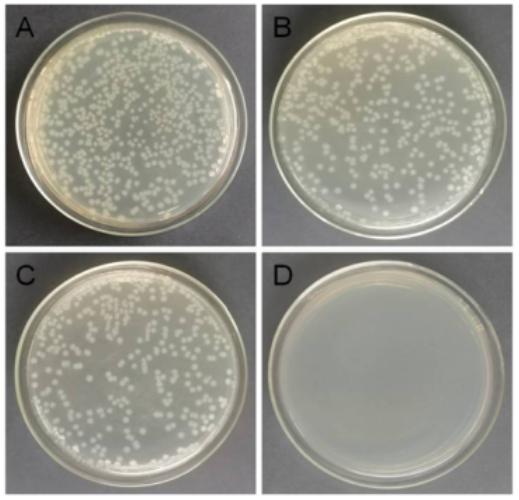

納米酶因其多樣的酶催化活性而備受關(guān)注。但是構(gòu)建具有強(qiáng)大催化活性的新型納米酶仍然存在挑戰(zhàn)。這里,報(bào)道了一種原子級分散且完全暴露的Cu3簇,其穩(wěn)定在富含缺陷的納米金剛石-石墨烯雜化載體(Cu3/ND@G)上,該載體具有獨(dú)特的活性吸附位點(diǎn),有利于O2的吸附和裂解,從而增強(qiáng)類似氧化酶的活性和抗菌活性。研究表明,Cu3/ND@G的催化速率常數(shù)(Kcat = 1.474×10-1 s-1)高于之前報(bào)道的Cu單原子氧化酶模擬物(0.5×10-3 s-1),甚至優(yōu)于商業(yè)Pt/C (1.01×10-2 s-1)。密度泛函理論計(jì)算表明,原子分散的Cu3簇作為活性中心顯著提高了類似氧化酶的活性,這歸因于O2容易分解成活性氧物種(•OH)。原子級分散的Cu3簇在NaAc緩沖液中具有100%的抗菌率,顯示了其在抗菌材料領(lǐng)域的潛在應(yīng)用。

Figure 1. Cu-NPs/ND@G 和 Cu3/ND@G 的形態(tài)表征。Cu-NPs/ND@G 在低 (A) 和高 (B) 倍率下的 AC-HAADF-STEM 圖像。Cu3/ND@G 在低 (C) 和高 (D) 倍率下的 AC-HAADF-STEM 圖像。

Figure 2. Cu-NPs/ND@G和Cu3/ND@G 的結(jié)構(gòu)表征。(A) Cu-NPs/ND@G 和 Cu3/ND@G 的XRD圖。(B) XPS 光譜。 (C) Cu-NPs/ND@G、Cu3/ND@G、CuO 和Cu箔的Cu K邊緣XANES 光譜和 (D)傅立葉變換 (FT)。

Figure 3.Cu-NPs/ND@G和Cu3/ND@G 的類似氧化酶樣活性。(A) 在空氣飽和的NaAc緩沖溶液中的典型米氏圖。(B) 在O2飽和、空氣飽和、以及N2飽和的 NaAc 緩沖液條件下,Cu3/ND@G 的紫外-可見 (UV-vis) 吸收光譜。(C) Cu-NPs/ND@G和(D) Cu3/ND@G在空氣飽和的NaAc緩沖溶液(pH = 4.5)中生成DMPO/•OH 加合物的ESR譜圖。
Figure 4.Cu-NPs/ND@G和Cu3/ND@G的抗菌性能。生長抑制試驗(yàn):將不同的材料和菌液涂在LB瓊脂平板上,用大腸桿菌培養(yǎng),分別用用(A)空白、(B) ND@G、(C) Cu-NPs/ND@G和(D) Cu3/ND@G處理,培養(yǎng)條件:37℃和24 h。
該研究工作由遼寧大學(xué)Lini Yang和Lixin Xia課題組于2021年發(fā)表在Applied Catalysis B: Environmental期刊上。原文:Defect-rich graphene stabilized atomically dispersed Cu3 clusters with enhanced oxidase-like activity for antibacterial applications。
轉(zhuǎn)自《石墨烯研究》公眾號